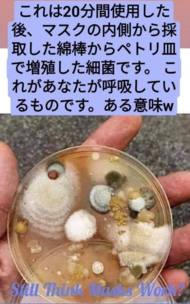

健康と病気板
書き込む前にお読み下さい→インフォメーション
画像投稿は引用の範囲内でお願い致します。
健康と病気について語り合う掲示板です。
●レス上限 500件 ●スレ寿命 無期限 ●画像アップ上限 2048KB ●レス画アップ上限 2048KB ●age幅 96 ●連投 8/10
| ▼スレ立て日時順 |
|
スレ:2021/10/18(月) 08:21
レス:2021/11/09(月) 11:44
|
スレ:2021/11/08(月) 20:18
レス:2021/11/08(月) 23:21
|
スレ:2021/04/21(水) 11:09
レス:2021/11/07(水) 00:03
|
スレ:2021/10/31(日) 21:41
レス:2021/11/04(日) 15:55
|
|
スレ:2021/10/29(金) 23:09
レス:2021/11/03(金) 06:26
|
スレ:2021/11/01(月) 20:42
レス:2021/11/02(月) 03:50
|
スレ:2021/11/01(月) 07:25
レス:2021/11/01(月) 11:09
|
スレ:2021/10/30(土) 18:46
レス:2021/10/31(土) 17:50
|
|
スレ:2021/07/13(火) 14:51
レス:2021/12/09(火) 10:36
|
スレ:2021/10/27(水) 07:07
レス:2021/10/28(水) 21:56
|
スレ:2021/10/26(火) 00:26
レス:2021/10/26(火) 07:35
|
スレ:2021/10/24(日) 11:46
レス:2021/10/25(日) 22:56
|
|
|
|||
|
スレ:2021/10/01(金) 10:34
レス:2021/10/25(金) 21:22
|
スレ:2021/10/23(土) 01:20
レス:2021/10/24(土) 13:08
|
スレ:2021/10/23(土) 20:08
レス:2021/10/24(土) 11:48
|
スレ:2021/10/22(金) 07:00
レス:2021/10/23(金) 18:39
|
|
スレ:2021/09/28(火) 19:28
レス:2021/10/23(火) 14:47
|
スレ:2020/11/14(土) 18:43
レス:2025/11/03(土) 20:22
|
スレ:2021/10/03(日) 18:35
レス:2021/10/22(日) 23:22
|
スレ:2021/10/21(木) 10:54
レス:2021/10/21(木) 18:33
|
|
スレ:2021/10/21(木) 15:48
レス:2021/10/21(木) 15:48
|
スレ:2021/10/11(月) 08:19
レス:2021/10/20(月) 22:58
|
スレ:2021/10/20(水) 09:37
レス:2021/10/20(水) 18:50
|
スレ:2021/10/15(金) 08:22
レス:2021/10/19(金) 23:16
|
|
|
|||
|
スレ:2021/10/18(月) 20:03
レス:2021/10/19(月) 06:08
|
スレ:2021/10/17(日) 08:23
レス:2021/10/17(日) 23:11
|
スレ:2021/10/17(日) 20:10
レス:2021/10/17(日) 20:10
|
スレ:2021/10/17(日) 19:56
レス:2021/10/17(日) 19:56
|
|
スレ:2021/10/14(木) 02:19
レス:2021/10/15(木) 00:08
|
スレ:2021/10/09(土) 08:00
レス:2021/10/14(土) 22:51
|
スレ:2021/09/11(土) 08:56
レス:2021/10/12(土) 20:32
|
スレ:2021/09/12(日) 05:36
レス:2021/10/06(日) 21:15
|
|
スレ:2021/09/23(木) 10:32
レス:2021/10/06(木) 15:38
|
スレ:2021/09/13(月) 06:07
レス:2021/10/06(月) 06:33
|
スレ:2021/10/03(日) 08:35
レス:2021/10/03(日) 16:34
|
スレ:2020/04/21(火) 16:37
レス:2021/10/15(火) 00:14
|
|
|
|||
|
スレ:2021/06/09(水) 21:56
レス:2021/11/05(水) 22:35
|
スレ:2021/07/10(土) 16:15
レス:2021/10/02(土) 15:34
|
スレ:2021/09/18(土) 06:56
レス:2021/09/23(土) 22:15
|
スレ:2021/09/21(火) 17:22
レス:2021/09/22(火) 22:33
|
|
スレ:2021/06/02(水) 06:07
レス:2021/11/01(水) 06:13
|
スレ:2021/08/23(月) 20:18
レス:2021/09/22(月) 18:10
|
スレ:2021/06/14(月) 14:30
レス:2021/09/22(月) 09:35
|
スレ:2021/08/30(月) 10:33
レス:2021/09/21(月) 17:20
|
|
スレ:2021/09/21(火) 00:11
レス:2021/09/21(火) 00:11
|
スレ:2021/09/16(木) 01:39
レス:2021/09/16(木) 01:39
|
スレ:2021/07/24(土) 01:55
レス:2021/09/15(土) 23:05
|
スレ:2021/03/17(水) 21:29
レス:2021/09/15(水) 18:33
|
|
|
|||
1
2
3
4
5
6
7
8
9
10
11
12
13
14
15
16
17
18
19
20
21
22
23
24
25
26
27
28
29
30
31
32
33
34
35
36
37
38
39
40
41
42
43
44
45
46
47
48
49
50
51
52
53
54
55
56
57